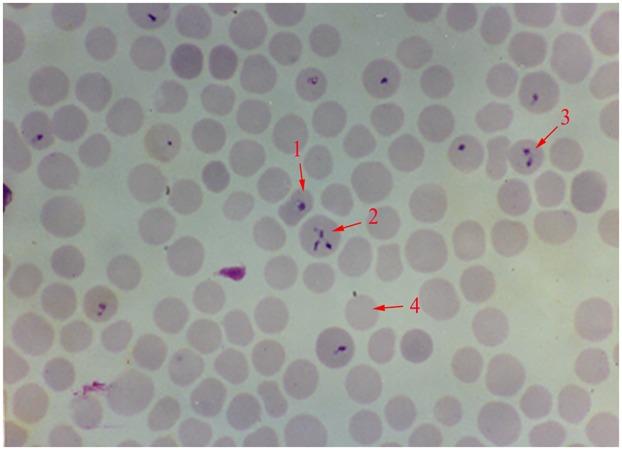

关于一种感染水牛的原生动物寄生虫的研究历史概述
A Historical Overview of Research on , a Protozoan Parasite Infecting Water Buffalo.
作者信息
He Lan, Liu Qin, Yao Baoan, Zhou Yanqin, Hu Min, Fang Rui, Zhao Junlong
机构信息
State Key Laboratory of Agricultural Microbiology, College of Veterinary Medicine, Huazhong Agricultural UniversityWuhan, China.
Key Laboratory of Development of Veterinary Diagnostic Products, Ministry of Agriculture, Huazhong Agricultural UniversityWuhan, China.
出版信息
Front Microbiol. 2017 Jul 14;8:1323. doi: 10.3389/fmicb.2017.01323. eCollection 2017.
is a globally important zoonotic disease caused by tick-borne intraerythrocytic protozoan of the genus (phylum apicomplexa). In China, there are five species that infect cattle buffalo and cause great economic loss, which include , , , , and . Among them, is the most recently identified new species epidemic in China. This review summarized the work done in the past 33 years to give an overview of what learned about this parasite. This parasitic protozoan was found in 1984 in Central and South China and then named as in 1997 based on its differences in transmitting host, morphology, pathogenicity and characteristics of cultivation when compared with and . It was found that is the transmitting vector and water buffalo is the only reported host. Phylogenetic analysis based on the 18S rRNA gene also confirmed that is a new species. After species verification, four diagnostic methods including semi-nest PCR, loop-mediated isothermal amplification assay, reverse line blot hybridization assay, and real-time PCR were established for lab and field use purposes. Genomic sequencing was conducted and the complete genomes of mitochondria and apicoplast were annotated. Future work will be focused on developing effective vaccines, identifying drug targets and screening useful drugs for controlling in water buffalo.
是一种由蜱传播的巴贝斯属(顶复门)红细胞内原生动物引起的全球重要人畜共患病。在中国,有五种感染牛和水牛并造成巨大经济损失的物种,包括、、、和。其中,是中国最近发现的新的物种疫情。这篇综述总结了过去33年所做的工作,以概述对这种寄生虫的了解。这种寄生原生动物于1984年在中国中部和南部被发现,然后在1997年根据其与和相比在传播宿主、形态、致病性和培养特性方面的差异被命名为。发现是传播媒介,水牛是唯一报道的宿主。基于18S rRNA基因的系统发育分析也证实是一个新物种。经过物种鉴定,建立了包括半巢式PCR、环介导等温扩增法、反向线印迹杂交法和实时PCR在内的四种诊断方法,用于实验室和现场。进行了基因组测序,并注释了线粒体和质体的完整基因组。未来的工作将集中在开发有效的疫苗、确定药物靶点和筛选用于控制水牛的有用药物。